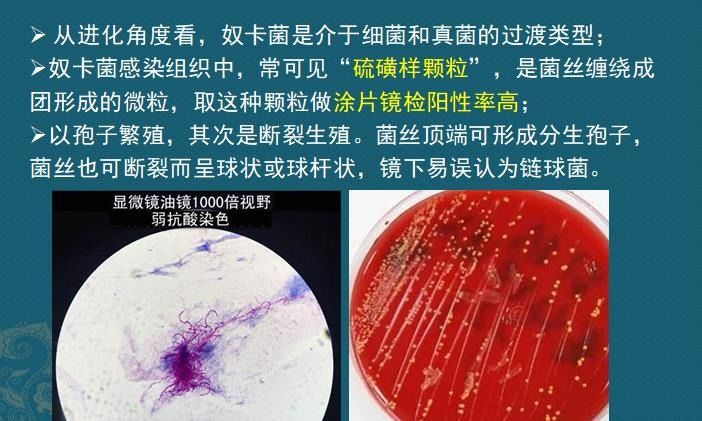
这个细菌提醒你，别买病死的鱼，它是个吃草的细菌，后来学会吃鱼

序章
宇宙大爆炸创造了地球,安排上帝来当董事长。
上帝上任之后,给地球安排的第1届董事会董事是恐龙,对,包括吃肉恐龙和吃草恐龙。

但经过一个大约1亿6千万年的运营,地球生态环境可持续发展有限责任公司,倒闭了……
上帝清查账目,发现公司倒闭的原因是恐龙们体型太庞大,太能吃了,把地表搞得乌烟瘴气,有颗天外陨石看不下去了,飞过来,轰……
上帝就思考了一下,看来地球董事会成员体型太庞大了不行,那下一届就反其道而行之吧,于是上帝制造了肉眼看不见的微生物来当下一届,主要是细菌!
第一章,草木枯荣,动植物死生循环的意义
地球上繁衍着数不清的动物和植物,它们死亡后怎么处置呢?会不会尸积如山,落叶似海?
不会,上帝把这个分解任务交给了新董事会成员——细菌!跟恐龙一样,细菌也分为吃肉的细菌和吃草的细菌,分别分解肉类和植物类。

如图,金黄色葡萄球菌和铜绿假单胞菌(绿脓杆菌)为代表的细菌吃肉(当然还包括某些霉菌),负责分解掉地球上的动物尸首,实现肉食类资源循环。所以很多死亡的动物尸首就算没有被野兽吃掉,也会被细菌分解掉,免得脏了地表环境,毕竟动物们都没有学会土葬。
那么,衰老的植物怎么办呢?
这就要提到今天的主角——奴卡菌。
以奴卡菌为代表的吃草类细菌,会分解树叶,负责把地球上的各种枯叶植物分解成泥土,实现植物类资源的循环。

实际上,树叶类植物能够提供碳源和氮源,这是奴卡菌生长所需要的养料。
所以分解地球上的衰老植物,让落叶归根枯叶化土,这个光荣的任务就交给了奴卡菌来完成,昼夜不停,但四季轮休(春、冬季会安排长假休息)。
后来,到了雨季瓢泼大雨,很多落叶被冲进江河湖海,奴卡菌也被冲进了水里。
进了水里才发现,原来奴卡菌是个近视眼,它把水里的鱼类也当成了树叶:

也难怪,以豪大夫300度的近视,摘掉眼镜远远看,这条鱼也实在很像一片树叶。
好的,奴卡菌们说,弟兄们开工了,冲上去,分解吸收它的碳源和氮源,把鱼肉也变成泥土,完成我们的使命,吼吼,结果就发生了鱼的奴卡菌感染(这是养殖户的噩梦)。

也就是说在机缘巧合之下,吃草的奴卡菌也学会了吃肉,这增强了它的生存能力!所以奴卡菌可见于土壤、腐叶、淡水和海水等等,在我们地球表面几乎随处可见。
第二章,假如人类招惹了奴卡菌
如果在干燥、温暖的季节,奴卡菌随着空气中的气溶胶微粒被吸入人类肺内,这个近视眼的细菌会把人类的肺叶也误看成树叶,粘上去,分解,就会发生人类肺脏的感染,引起肺部肉芽肿性炎症和化脓性炎症(奴卡菌肺炎),甚至随血液播散引起脑脓肿。

上图右边这张CT片,这位女士感染了奴卡菌,在双肺形成了结节样和空洞样病灶,就像左边的鱼类感染一样的特点。
而有些老人消化功能减退,又勤俭持家,舍不得扔掉腐败的水果,也可以经消化道感染奴卡菌。

有的人不讲究腿部卫生,挠破了皮,或者野外被树枝划伤,或者有糖尿病等原因造成身体抵抗力下降,也会发生四肢的奴卡菌感染,像上图鱼类感染一样,腐烂出一个空洞,多见于小腿和足部,称为足菌肿,引起这种感染的多为巴西奴卡菌。

这里就产生了一个问题:为什么奴卡菌感染容易发生空洞呢?
的确,无论是鱼感染还是人肺炎,无论是鱼背、人肺,还是皮肤,都容易烂出空洞。这是为什么呢?
我们需要从显微镜下,把奴卡菌放大了观察,寻找真相——

如上图,显微镜下放大后的奴卡菌(左图红色),飘着很多菌丝,就像树根一样盘绕着被它感染的组织,等这些组织炎症坏死之后,就像树根上带着泥巴一样被拽出来,就在原来位置上形成了空洞。
奴卡菌生来就带有泥土味道,所以病人的痰液会有土腥味;另外,奴卡菌的菌落像硫磺颗粒一样,所以奴卡菌肺炎的病人,会咳出像硫磺一样稠厚的痰液(如下图),考虑到这个颜色有点叫人反胃,豪大夫把图片处理成了灰色:

但这种痰液对病人的诊断意义太重要!因为很多奴卡菌肺炎表现不典型,常规抗生素又往往不敏感,容易造成延误治疗,建议肺炎病人保留好自己的痰液,给呼吸科医生瞅瞅,不同细菌感染常常呈现不同颜色性状,对提示诊断很有意义。
第三章,奴卡菌肺炎的CT片怎样诊断
奴卡菌是一种条件致病菌,健康人少见,免疫缺陷的人多见,包括艾滋病患者、慢阻肺和应用激素、器管移植、恶性肿瘤化疗等等情况。
在所有感染者中,免疫力正常的人大约占15-38%,免疫力下降的人群占大多数。其中艾滋病患者发生感染的几率约为一般人群的140倍;各种原因所致结构性肺病如支气管扩张、慢阻肺等可能是重要的风险因素。
各类慢性消耗者常常出现低蛋白血症,所以当肺部出现不明原因肺炎,同时伴有低蛋白血症,尤其是常规抗生素治疗无效时,要高度警惕诺卡菌感染。
1.早期的奴卡菌肺炎
早期感染在CT片上缺乏特征性,就像下面这些鲈鱼一样:

表现为支气管壁增厚,周围小叶中心性结节、多发树芽征、支气管扩张等,跟其他的化脓性肺炎早期CT表现很相似,不好鉴别,需要借助痰液性状、病人的免疫状态、细菌培养等多种检查方式来鉴别诊断。
2.进展期奴卡菌肺炎
有一定特点,包括:
1.局限或弥漫性肺部磨玻璃影、斑片状影、肺实变等;
2.单个或多个结节、团块状影,结节大小不等,早期可以呈多发粟粒状;
3.空洞常见,因为奴卡菌引起的是化脓性感染,病变肺组织坏死后随痰液排出,会形成空洞,但空洞内极少见到液平面(烂鱼肉状坏死,被菌丝盘绕);
4.累及胸膜可出现胸痛及脓胸。

其实跟鱼类感染类似,左图的鲈鱼因感染奴卡菌死亡,解剖发现内脏都烂掉了,像人类的坏死肺组织一样(右图)。
终章,奴卡菌的治疗
这个细菌以前一般首选磺胺类药(复发新诺明),但近年来发现磺胺类药耐药率较高,多主张参照药敏试验联合用药。此外,奴卡菌对氨基糖苷类、部分头孢菌素类、碳青霉烯类和喹诺酮类药物也敏感。利奈唑胺几乎对所有的奴卡菌敏感,有潜力成为首选药物。
需要注意的是,奴卡菌感染的治疗周期较长!对免疫功能正常者的奴卡菌肺炎,疗程为3个月;对免疫抑制的病人,需要治疗6个月以上;有中枢神经系统播散的病人,应延长到12个月;对艾滋病继发感染的病人,需要12个月甚至更长时间。对免疫抑制的病人,建议低剂量维持治疗。如果出现脓胸、心包积液、抗菌治疗无效的脑脓肿等,通常需要手术治疗。
这种细菌感染如果不能及时诊断正确用药,会死人的!而且死亡率不低!

我是影像科豪大夫,分享小病例,传递正能量,欢迎关注!
#湖南医聊超能团# #清风计划# #健康科普排位赛#